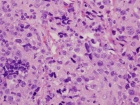
Zoom image: Cell stain
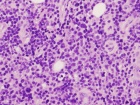
Zoom image: Cell stain

Case 6
41 year old male c/o left knee mass and swelling. He has a history of T-cell lymphoma diagnosed several years ago. He has been in remission for almost seven years. Six months prior, he began to experience left knee pain and swelling.
Upcoming Events
Import medical school events to your Exchange, Gmail, iPhone or iPod calendar. Customize your calendar by selecting different event categories and receive automatic reminders of the school events that matter most to you.